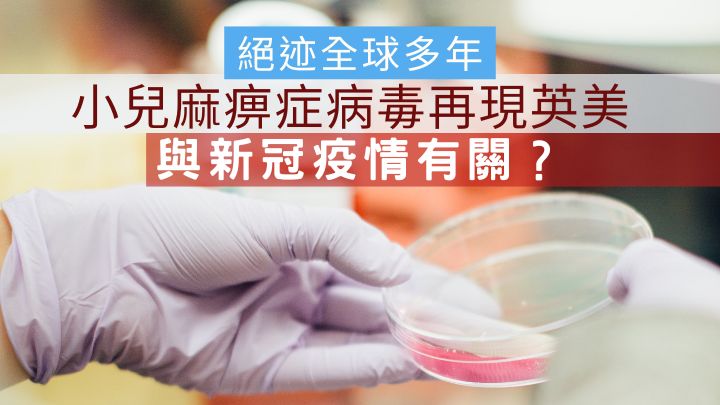

郑海泉离世|儿时患小儿麻痹症 这绝迹多年病毒 月前再现英美 与新冠疫情有关?
发布时间:11:47 2022-08-30 HKT
汇丰前亚太区主席、汇丰首位华人大班郑海泉前晚离世,终年74岁, 其励志的奋斗经历,为人津津乐道,即使出身基层,儿时又因患病而致不良于行,仍能成功活出积极向上、出人头地的精采人生。
英美再现「毒踪」
令致郑海泉不良于行的疾病,是本来早已绝迹多国多年的小儿麻痹症。此症是由脊髓灰质炎病毒引致,自1988年以来,全球小儿麻痹症病例减少达99%以上,随着多年来疫苗接种的帮助下,此症已「绝迹」于大部分国家及地区,只有巴基斯坦、阿富汗两国目前仍未完全消灭小儿麻痹症。 然而近日,美国纽约及英国伦敦却分别于7月及6月,在当地发现小儿麻痹症病例,美国是近十年首次、英国更是近四十年首次再出现病例。
非儿童才会患上
据悉,美国的患者是一名成年人,肌肉已出现瘫痪,未能确定其感染来源。此乃美国自2013年首次发现的病例,因美国自1979年以来,已未曾再有发现本土传播的小儿麻痹症,故专家估计,患者有可能是从其他国家感染。
至于英国,则是在伦敦区内多个污水样本中,发现小儿麻痹症病毒,这是英国自1984年以来,近四十年首次发现小儿麻痹症病毒,当局指病毒有可能已在社区内传播。
估计与新冠疫情有关
据统计,2016 年全球只录得四个国家数十宗小儿麻痹症病例,但自 2019到2020年,全球病例已出现急增,超过了一千倍,病例分别发生于三十多个国家。来自加拿大的专家因此估计,小儿麻痹症再度重临的原因,与新冠疫情爆发,疫情扰乱了婴童接种此症的疫苗进程有关。因为小儿麻痹症疫苗需要在出生后一年内接种,并且往后要再补打多针加强剂,而疫苗免疫率甚高,故一般只有未接种疫苗人士(尤其幼童),才会受感染或出现严重个案。

高传染性且无药可治
患者可能会出现发烧、头痛、呕吐、腹部不适、肌肉疼痛、颈背僵硬及麻痹等症状。大部分患者都可痊瘉,但严重者可导致永久伤残、肌肉瘫痪,甚至死亡。
此病具有高度传染性,病毒主要经口粪途径由人传人,从口部进入人体,最终入侵中枢神经系统。现时并没有药物治疗此症 ,患者必须送院接受治理及隔离 。因患者的粪便带有病毒,故照顾患者时,必须加倍注意衞生。
确保完成疫苗接种
最有效预防此症方法是接种疫苗,世衞建议由没有受小儿麻痹症影响的地方,到访受小儿麻痹症影响的地区前,应先确保已完成小儿麻痹症疫苗系列的接种。若从未接种疫苗,应在出发前完成接种。另应建立良好的个人及食物衞生习惯,进食或处理食物前及如厕后均要洗手,避免食用/饮用怀疑受污染的食物或饮品。
想知更多健康资讯 请到WeCare Health专页浏览 按此
(https://www.facebook.com/wecarehealthhk)

立即下载 | 全新《星岛头条》APP:https://bit.ly/3yLrgYZ






























